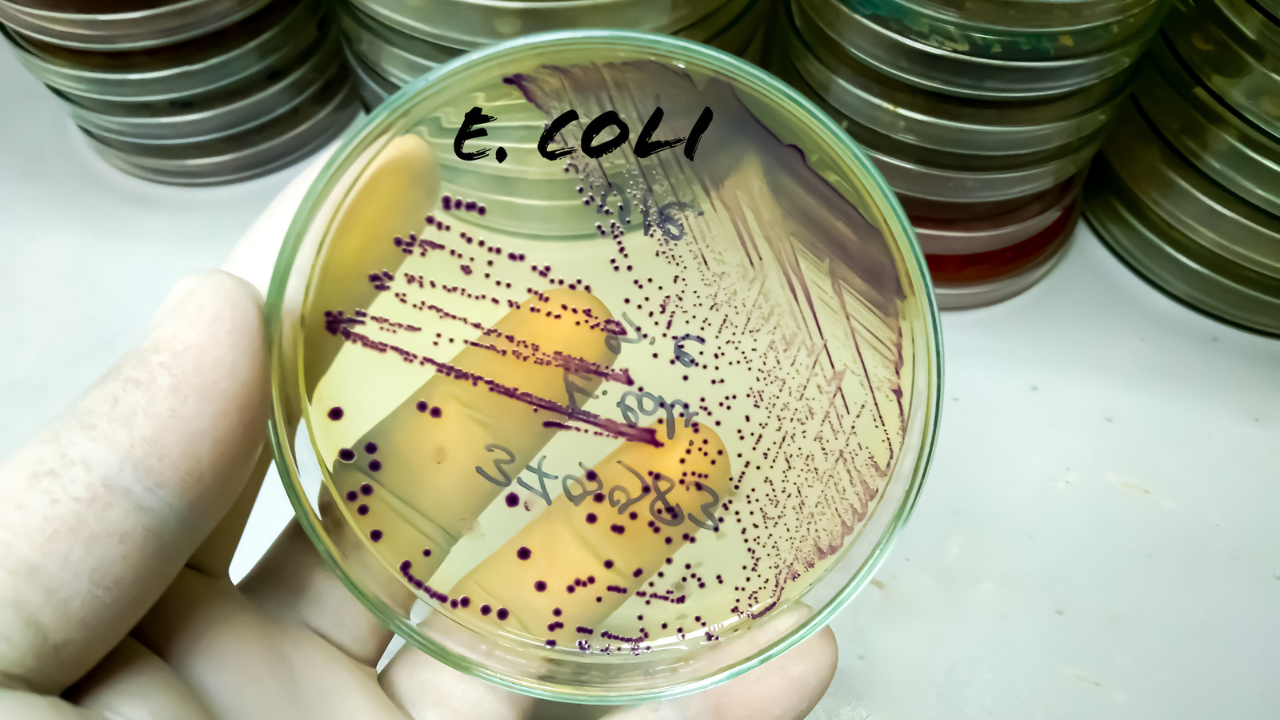
indore water contamination: what is e. coli, faecal bacteria, and how can they kill?

In the Bhagirathpura locality of Indore (often also celebrated as the country’s cleanest city), the end of the year was marked by unusual water quality. There was a foul smell, visible discoloration and
the water even tasted bitter. This was preceded by the reports of a widespread illness throughout the area. Local residents began developing symptoms of diarrhea, dehydration, vomiting and high fever after consuming municipal drinking water. This later prompted mass hospital visits where the crisis quickly escalated into a waterborne disease outbreak. So far, 10 deaths have been confirmed along with hundreds of other sick patients who are admitted in hospitals for treatment. Meanwhile, as the police and doctors investigate for the cause of the waterborne illness outbreak, the lab tests of water supplied through the Narmada pipeline in Bhagirathpura (the epicentre of the outbreak), have revealed extremely high levels of contamination. According to the officials on the case, water samples have tested positive for fecal coliform, E. coli and Klebsiella bacteria. Exposure to all and any three of these lead to vomiting and diarrhoea. Sources have also mentioned that the samples showed additional traces of Vibrio cholerae-like elements, the bacteria that is commonly associated with cholera. So far, around 80 water samples have been tested and more detailed lab reports are expected to reach within a couple of days. Read more: Donald Trump Blames Aspirin for Bruised Hand, Dismisses Health Concerns
How did the contamination happen?
Health authorities involved in the case have explained that the contamination occurred after aleak near a police check post in Bhagirathpura led to sewage water seeping into the main drinking water pipeline. Officials also suspect that the waste from a toilet at the police outpost was improperly diverted to land into a pit instead of being connected to the sewage network. This led to sewage mixing with the regular water supply.
What is E.Coli and how is it harmful?
E. coli (Escherichia coli) and other faecal bacteria are known to be microorganisms that are commonly found in the intestines of animals and humans. While there exist many strains that are harmless, there are also some that can turn deadly when mixed with drinking water, that is exactly what happened in the Indore waterborne illness outbreak case. When sewage leaks into water pipelines, it allows these bacteria to spread rapidly through households, exposing entire communities.Once in the system, the harmful strains of E.coli happen to attack the digestive system almost immediately. This leads to severe diarrhoea, abdominal cramps, vomiting and dehydration. In more vulnerable groups like children and the elderly, the ones who have a weak immunity system, this fluid loss can quickly turn life-threatening also. Some strains are also known to release toxins that damage the lining of the intestines and in extreme cases, also affect the bloodstream and kidneys, leading to complete organ failure or sepsis.
Faecal contamination in water is particularly dangerous because it often goes unnoticed. The water may look clean but still carry bacteria capable of triggering outbreaks within days. Without timely medical care, prolonged diarrhoea can cause electrolyte imbalance, shock, and death.According to the Chief Medical and Health Officer, residents began reporting the issue to hospitals earlier this week with complaints of diarrhoea, fever and vomiting. So far, more than 1400 people have fallen ill. Health department teams are also doing door-to-door surveys in over 1700 households and examining more than 8500 residents.
Read more: Constant Throat Clearing? It Could Be Laryngopharyngeal Reflux, Not a Habit
/images/ppid_a911dc6a-image-17673376367446552.webp)

/images/ppid_a911dc6a-image-177077043838376354.webp)









